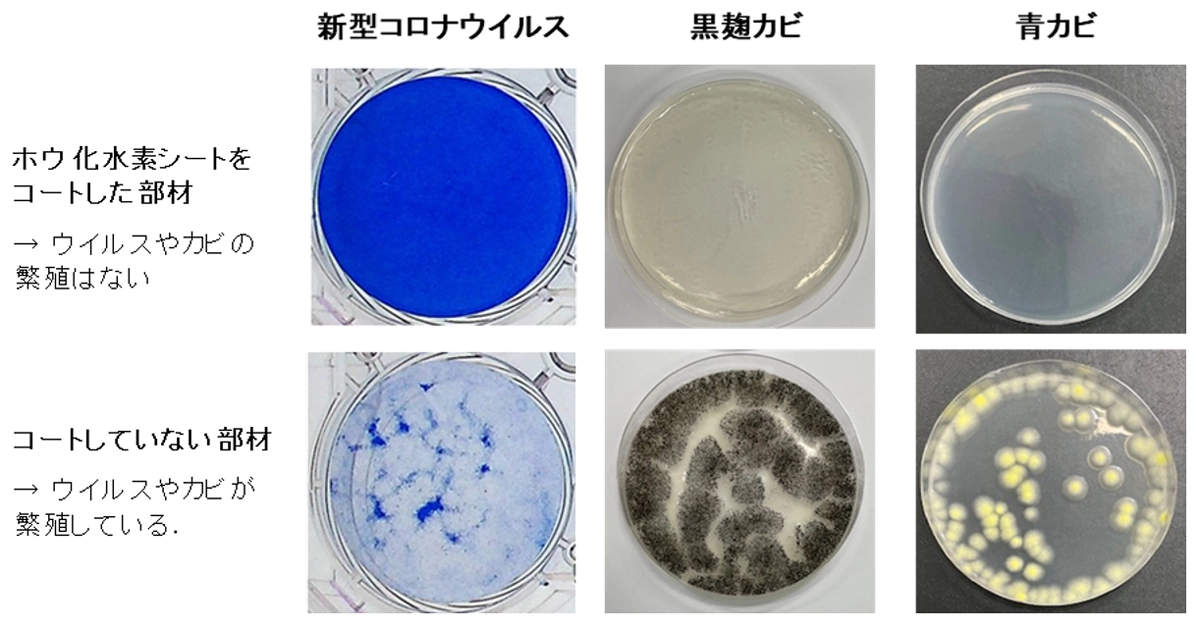

ポイント
- ホウ化水素シートが抗菌・抗ウイルス・抗カビ機能を発現
- 透明なコーティング材としての応用に期待
- 感染リスク低減や身のまわりの清潔を保つ部材や日用品への応用に期待
概要
東京科学大学(Science Tokyo)物質理工学院 材料系の宮内雅浩教授、山口晃准教授、Andi Mauliana(アンディ・マウリアナ)大学院生(博士後期課程2年)、筑波大学 数理物質系の近藤剛弘教授、高知工科大学 理工学群の藤田武志教授、神奈川県立産業技術総合研究所(KISTEC)の砂田香矢乃常勤研究員、小林慶一研究員、永井武上席研究員、石黒斉プロジェクトリーダーらの研究チームは、ホウ化水素シート[用語1]が優れた抗菌・抗ウイルス・抗カビ機能を発揮することを見出しました。
ホウ化水素シートは筑波大学の近藤剛弘教授らが発明した二次元物質[用語2]で、水素キャリア[用語3]や触媒などへの応用が期待されている物質です。本研究では、このホウ化水素シートをガラス基板にコートした透明な膜部材が、優れた抗菌・抗ウイルス・抗カビ機能を示すことを明らかにしました。高性能のメカニズムについて検証した結果、ホウ化水素シートが微生物のタンパク質の変性に寄与することが分かりました。新型コロナウイルス感染拡大のようなパンデミック[用語4]が再び起こる恐れがあるなか、ホウ化水素シートはこうした感染リスク拡大を防止するための部材や繊維類などへの透明コーティング材としての応用が期待できます。また、抗カビ機能も有することから、身のまわりの清潔を保つための部材や日用品への応用も期待できます。
本成果は、4月23日付の「Journal of Materials Chemistry B」誌に掲載されました。
背景
新型コロナウイルス感染拡大のようなパンデミックが再び起こる恐れがあるなか、感染予防対策は非常に重要です。特に、生活空間での感染予防のため、固体状で抗菌・抗ウイルス効果が持続し、部材へのコーティングや複合化が可能な材料の開発が求められていました。また、光触媒に要する光照射や、特殊な装置を用いない、簡便な感染予防技術も求められています。
研究成果
ホウ化水素シートは筑波大学の近藤剛弘教授らが発明した物質で、簡便で大量合成可能な溶液プロセスで合成することができます[参考文献1、2]。図2(a)の透過型電子顕微鏡像が示す通り、ホウ化水素シートはナノシート状の二次元物質です。また、ホウ化水素シート2.0 mgをガラス基材にコートした薄膜の断面の走査型電子顕微鏡像を図2(b)に、コート部材の光透過率を図2(c)に示します。コートの膜厚は約2μmで、可視光領域の透過率は80%以上を示し、肉眼ではほぼ透明です。

次に、ホウ化水素シート膜の抗菌・抗ウイルス試験の結果を図3に示します。2.0 mgのホウ化水素シートをガラス基材にコートした部材に、黄色ブドウ球菌、大腸菌を接触させると、いずれも10分以内で生菌数が検出限界値以下まで減少しました。また、新型コロナウイルス、インフルエンザウイルス、ネコカリシウイルスを用いて同様の実験を行ったところ、いずれも接触時間10分以内でウイルス感染価[用語5]が検出限界値以下まで減少しました。これらの結果から、ホウ化水素シートが高い抗菌・抗ウイルス機能を有することが分かります。

次に、ホウ化水素シートの抗カビ性能を評価した結果を図4に示します。この結果から、黒麹カビ、青カビのいずれに対しても優れた抗カビ効果を発揮することが分かりました。カビ抑制効果を活かし、身のまわりの清潔を保つための部材への応用が期待できます。

ホウ化水素シートの優れた抗菌・抗ウイルス効果のメカニズムについて、赤外分光法[用語6]やアルカリホスファターゼ[用語7]を用いた酵素活性試験などによって調べました。その結果、ホウ化水素シートは微生物の持つタンパク質を変性させる特性を有し、その結果、菌やウイルスを不活化させることが明らかになりました。一方で、動物細胞に対する害への懸念を調べるためホウ化水素シートの細胞毒性[用語8]も調べましたが、特に強い毒性が無いことも分かっています。
社会的インパクト
ホウ化水素シートは感染リスクを低減するための部材や繊維類などへの透明コーティング材としての応用が期待できます。また、抗カビ機能も有することから、身のまわりの清潔を保つための部材や日用品への応用も期待できます。
今後の展開
さまざまな部材に適用するため、バインダーなどと複合化したコーティング剤を開発する予定です。また、安全・安心・健康促進・キレイな環境づくりに貢献できるさまざまな部材の開発につながることを期待しています。
参考文献
- [1]
- 特許第7057569号「二次元ホウ化水素含有シート、二次元ホウ素化合物含有シートの製造方法」、発明者:近藤剛弘、中村潤児、西野弘晃、藤野朝日、藤森智博、細野秀雄、宮内雅浩 特許権者:筑波大学、東京科学大学
- [2]
- H. Nishino, T. Fujita, N. T. Cuong, T. Tominaka, M. Miyauchi, S. Iimura, A. Hirata, N. Umezawa, S. Okada, E. Nishibori, A. Fujino, T. Fujimori, S. Ito, J. Nakamura, H. Hosono, T. Kondo*, “Formation and characterization of hydrogen boride sheets derived from MgB2 by ion exchange”; J. Am. Chem. Soc. 139, 13761, 2017.
用語説明
- [用語1]
- ホウ化水素シート:ホウ素と水素の組成比が1:1のナノシート状の物質。
- [用語2]
- 二次元物質:厚みが数nm程度以下のシート状の物質。
- [用語3]
- 水素キャリア:水素を貯蔵・輸送するための担体。高圧水素ガスボンベ、液化水素、アンモニア、有機ハイドライド、水素吸蔵合金などが知られる。
- [用語4]
- パンデミック:感染症や伝染病が世界的に大流行し、多くの感染者や患者が発生すること。
- [用語5]
- ウイルス感染価:感染力のあるウイルスの数。
- [用語6]
- 赤外分光法:赤外線を物質に照射して透過・反射した光を測定することによって、物質の構造を解析する方法。ホウ化水素シートのホウ素ー水素結合やタンパク質のアミド結合の等相互作用を分析することができる。
- [用語7]
- アルカリホスファターゼ:アルカリ性条件下でリン酸エステル化合物を加水分解する酵素。本研究では、この酵素活性を測定することで、タンパク質変性特性を評価した。
- [用語8]
- 細胞毒性:細胞に対して死、もしくは機能障害や増殖阻害の影響を与える性質。
論文情報
- 掲載誌:
- Journal of Materials Chemistry B
- タイトル:
- Broad-spectrum antimicrobial effects of hydrogen boride nanosheets
- 著者:
- Takeshi Nagai, Andi Mauliana, Keiichi Kobayashi, Akira Yamaguchi, Keisuke Miyazaki, Yue Yang, Jumpei Takeshita, Takeshi Fujita, Kayano Sunada, Hitoshi Ishiguro,* Takahiro Kondo, * and Masahiro Miyauchi *
- DOI:
- 10.1039/D4TB02854F
研究者プロフィール
宮内 雅浩 Masahiro MIYAUCHI
東京科学大学 物質理工学院 材料系 教授
研究分野:無機光機能性材料
近藤 剛弘 Takahiro KONDO
筑波大学 数理物質系 教授
研究分野:ナノ物質科学
藤田 武志 Takeshi FUJITA
高知工科大学 理工学群 教授
研究分野:金属組織制御
石黒 斉 Hitoshi ISHIGURO
神奈川県立産業技術総合研究所 次世代ライフサイエンス技術開発プロジェクト
プロジェクトリーダー
研究分野:応用分子細胞生物学
関連リンク
お問い合わせ
取材申込み
東京科学大学 総務企画部 広報課
- Tel
- 03-5734-2975
- Fax
- 03-5734-3661
- media@adm.isct.ac.jp